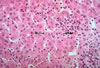

| inflamasyon |
inflamasyon |
| Çeşitli mikrobik ajanlar veya toksinlere karşı vücudun göstermiş olduğu sıcaklık artması, kızarıklık,ağrı ile karakterize iltihaplı reaksiyondur. Doku tepkisi-iltihaplanma.Yaralanmaya karşı dokunun gösterdiği reaksiyonlardır. Ağrı, ateşlenme, kızarma ve iltihaplanmadır. Örnek cümle: inflamasyon belirtileri: rubor, tumor, dolor, color olarak geçmektedir literatürde . |